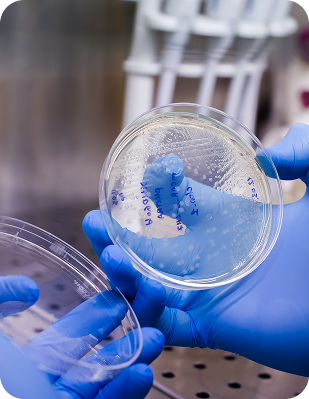

Ghép tế bào gốc
Ghép tế bào gốc tự thân là liệu pháp chuyên sâu, an toàn, giúp phục hồi mô và chức năng,
ứng dụng trong nhiều lĩnh vực điều trị và tái tạo.
Ghép tế bào gốc tự thân là liệu pháp chuyên sâu, an toàn, giúp phục hồi mô và chức năng,
ứng dụng trong nhiều lĩnh vực điều trị và tái tạo.

Tái tạo mô tổn thương & phục hồi chức năng cơ thể

Tăng cường miễn dịch, hỗ trợ điều trị bệnh mạn tính

Làm chậm lão hóa tế bào, trẻ hóa toàn diện

Không cần thuốc, không phẫu thuật, không xâm lấn

Sau khi được nuôi cấy, lưu trữ và kiểm định chất lượng, tế bào gốc sẽ được đưa vào ứng dụng trong các liệu trình điều trị, phục hồi và y học tái tạo.



Hoàn toàn an toàn vì sử dụng tế bào gốc tự thân, giảm thiểu tối đa nguy cơ thải ghép và phản ứng miễn dịch.
Người muốn phục hồi sức khỏe, trẻ hóa, cải thiện chức năng sinh lý hoặc hỗ trợ điều trị bệnh lý mạn tính.
Tùy từng liệu trình và thể trạng, hiệu quả có thể xuất hiện sau vài tuần và tiếp tục cải thiện theo thời gian.